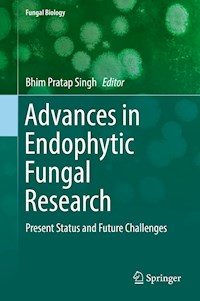
Advances in Endophytic Fungal Research - - E-Book

Advances in Endophytic Fungal Research E-Book
181,89 €
Mehr erfahren.
- Herausgeber: Springer International Publishing
- Kategorie: Wissenschaft und neue Technologien
- Serie: Fungal Biology
- Sprache: Englisch
Plant endophytes are a potential source for the production of bioactive compounds that can fight against devastating diseases in both plants and humans. Among these endophytic microorganisms, endophytic fungi are one of the dominant group of microorganisms with a potential role in plant growth promotion and the discovery of noble bioactive natural products. Endophytic fungi possess several bioactivities like anticancer, antimicrobial, insecticidal, plant growth stimulants, crop protection, phytoremediation, etc. Presence of modular biosynthetic genes clusters like PKS and NRPS in several endophytic fungi underscores the need to understand and explore such organisms. This volume presents and demonstrates the applied aspects of endophytic fungi. Practical applications of such endophytes are discussed in detail, including studies in pharmaceutical development and agricultural management of important microbial diseases. The beneficial effects that endophytic fungi provide to host plants—enhancing growth, increasing fitness, strengthening tolerance to abiotic and biotic stresses through secondary metabolites—are also discussed. The reader is provided with a comprehensive and detailed understanding of such relationships between endophytic fungi and their host.
Das E-Book können Sie in einer beliebigen App lesen, die das folgende Format unterstützt:
Veröffentlichungsjahr: 2019





























